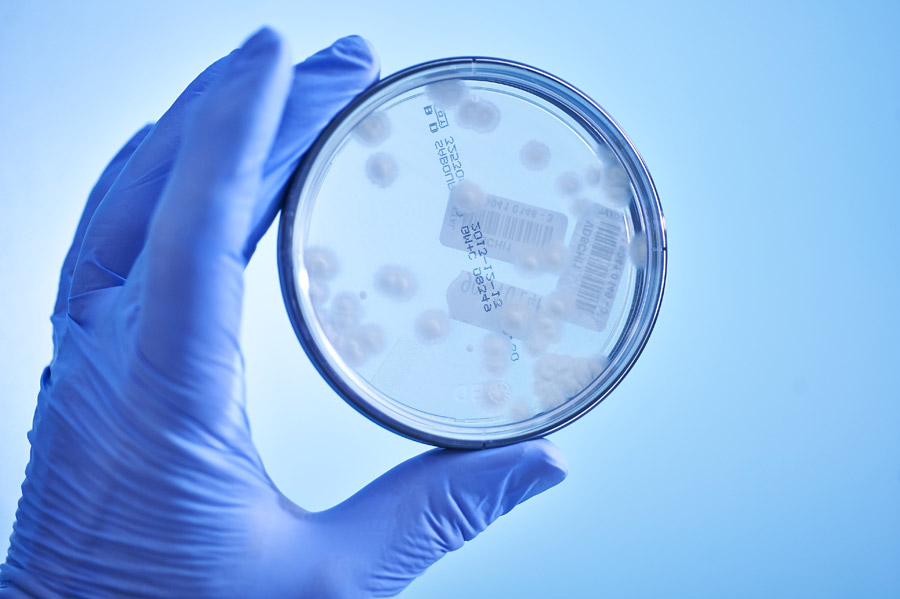

Od 27 listopada do 15 grudnia laboratorium oferuje wykonanie analiz pozwalających ocenić podstawowe funkcje organizmu w promocyjnej cenie 15 euro (wartość wg cennika to 35 euro).
Zestaw badań obejmuje:
- morfologię z rozmazem
- poziom żelaza
- wskaźniki stanu zapalnego: CRP
- parametry cukrzycowe: glukoza, HbA1c
- elektrolity: sód, potas, wapń, chlorki
- gospodarkę tłuszczową: cholesterol, trójglicerydy, HDL, LDL
- badania tarczycy: TSH
- badania wątroby: ALAT
- badania nerek: kreatynina, GFR
- poziom kwasu moczowego (czynnik rozwoju dny moczanowej)
Witamina D
Jej wpływ na prawidłowe działanie całego organizmu znajduje potwierdzenie w coraz większej ilości publikacji medyczno-naukowych. Oprócz znanego od dawna udziału w prawidłowym rozwoju układu kostnego, opisano jej rolę m.in. w procesach odpornościowych, w procesach chroniących układ sercowo-naczyniowy, w chorobach układu nerwowego, a nawet w chorobach nowotworowych. Niskie stężenie witaminy D we krwi zaburza procesy zachodzące w organizmie i istotnie zwiększa ryzyko rozwoju chorób przewlekłych.
Cena badania: 10 euro.
Ferrytyna - magazyn żelaza w organizmie
Ferrytyna to białko, które ma zdolność wiązania i magazynowanie żelaza. Zbyt mała podaż żelaza z pokarmem, zaburzenia wchłaniania lub jego nadmierna i niewyrównana utrata może w konsekwencji doprowadzić do niedokrwistości. Należy jednak pamiętać, że niedokrwistość z niedoboru żelaza rozwija się powoli. Nasz organizm jest przygotowany na sytuację krótkotrwałego niedoboru pierwiastka i początkowo wykorzystuje do syntezy hemoglobiny (barwnika krwi) żelazo zgromadzone w postaci m.in. ferrytyny. W przypadku przedłużającego się niedoboru żelaza, stężenie ferrytyny zaczyna spadać i jest jednym z pierwszych wskaźników rozwijającej się niedokrwistości (stężenia żelaza i hemoglobiny we krwi mogą być jeszcze zupełnie prawidłowe). To powód, dla którego badanie zaleca się wykonywać u dzieci, młodzieży, kobiet miesiączkujących i osób cierpiących z powodu zaburzeń układu pokarmowego.
Cena badania: 5 euro.
PSA (antygen sterczowy) i akcja Movember
Badanie jest kontynuacją akcji Movember (wkrótce więcej informacji), którą po raz kolejny w Słubicach organizują oldBOYS Słubice i portal Słubice24. IMD Oderland i Brandmed są partnerami medycznymi akcji. Dzięki ich zaangażowaniu panowie mogą zadbać o swoje zdrowie w promocyjnej cenie. Dla pierwszych 10 osób badanie PSA zostanie wykonane za darmo, a każdy kolejny mężczyzna, który zgłosi się do 15 grudnia zapłaci tylko 5 euro.
W przypadku wyniku nieprawidłowego, badania można rozszerzyć o oznaczenie tzw. wolnego PSA. Współczynnik wyliczony na podstawie tych dwóch badań ułatwia interpretację uzyskanych wyników.
Przed badaniem należy pamiętać, że intensywne uprawianie sportu, np. jazda na rowerze, badanie palpacyjne i USG gruczołu krokowego, mogą prowadzić do tymczasowego wzrostu poziomu PSA. Dlatego przed pobraniem krwi wskazane jest odczekanie co najmniej 24 godziny.
Cena badania: 5 euro.

Gdzie i kiedy na badania?
Pobrania krwi (na czczo) odbywają się w godzinach 7:10-11:00 (od poniedziałku do piątku) w punkcie pobrań IMD Labor Oderland znajdującym się w Centrum Medycznym Brandmed przy ul. Daszyńskiego 1 w Słubicach (budynek Galerii Prima, 2 piętro). Wyniki są wydawane w języku polskim.
W celu sprawnej obsługi pacjentów organizatorzy zachęcają do wcześniejsze rejestracji telefonicznej w godz. 7:00-20:00, pod numerem telefonu +48 95 758 2649.
Przy okazji korzystania z promocyjnej oferty, istnieje możliwość pobrania materiału także w kierunku innych badań oferowanych przez IMD Labor Oderland. O odpłatność należy pytać w punkcie pobrań.
[reklama]








